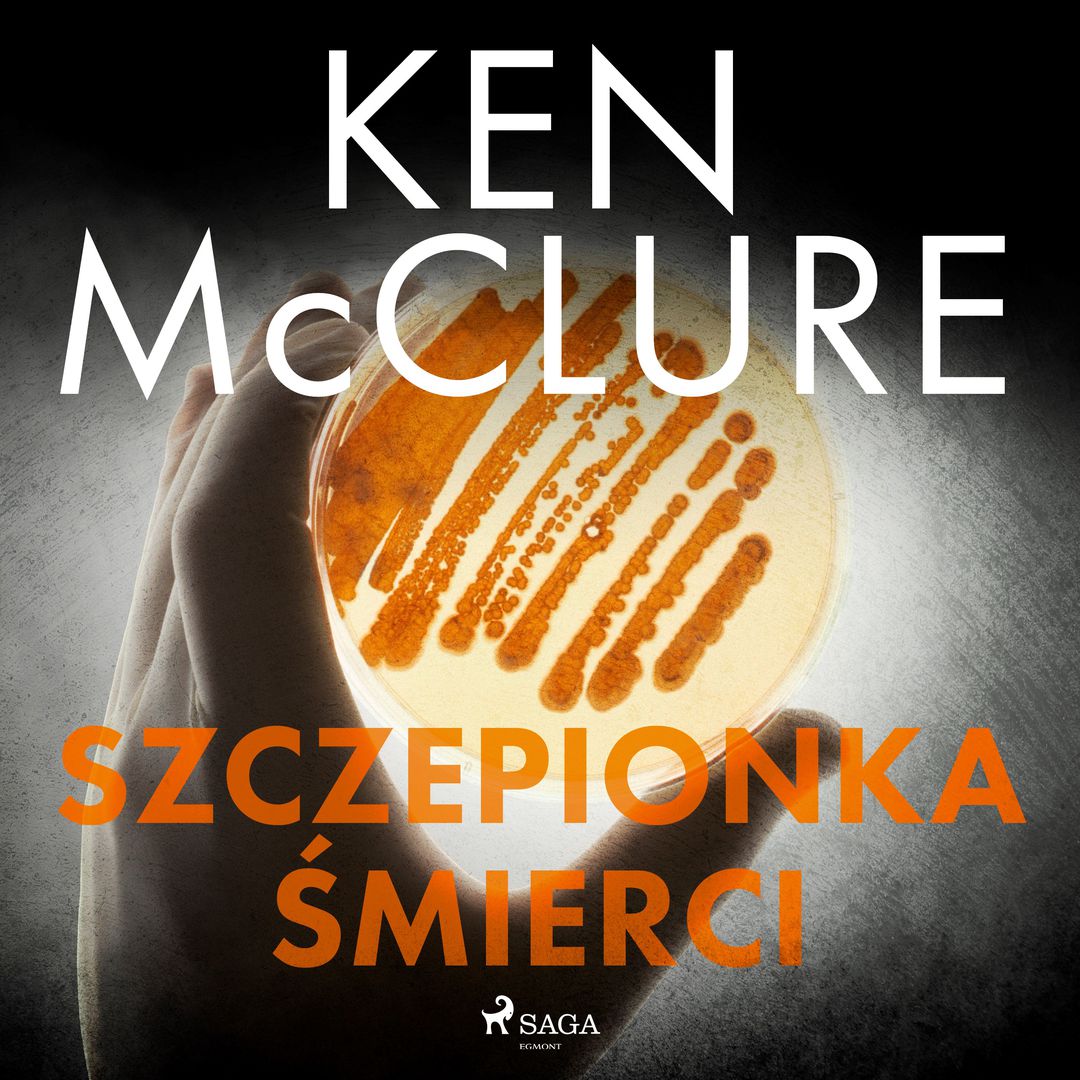
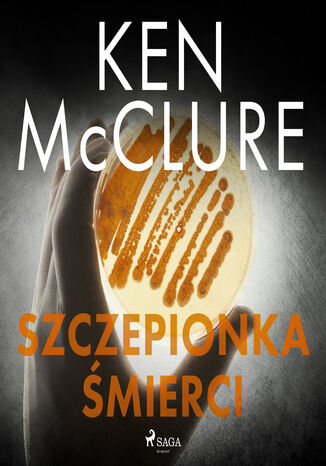

Szczepionka śmierci
| Tytuł oryginalny: | Lazarus strain |
|---|---|
| Autor: | Ken McClure |
| Tłumacz: | Krzysztof Uliszewski |
| Wyd. w latach: | 2007 - 2022 |
| Wydane w seriach: | Steven Dunbar |
| ISBN: | 9788728438213, 9788728438329 978-83-241-2832-7, 978-83-241-3657-5 |
| Autotagi: | dokumenty elektroniczne druk e-booki książki powieści proza |
| Więcej informacji... | |
|
|
|
|
|
|
Wypożycz w bibliotece
Kup
Recenzje
Opis
| Autor: | Ken McClure |
|---|---|
| Tłumacz: | Krzysztof Uliszewski |
| Lektor: | Anna Ryźlak |
| Wydawcy: | Saga Egmont (2022) Legimi (2022) ebookpoint BIBLIO (2022) IBUK Libra (2022) Wydawnictwo Amber (2007-2010) |
| Serie wydawnicze: | Steven Dunbar |
| ISBN: | 9788728438213 9788728438329 978-83-241-2832-7 978-83-241-3657-5 |
| Autotagi: | audiobooki beletrystyka dokumenty elektroniczne druk e-booki epika książki literatura literatura piękna nagrania powieści proza zasoby elektroniczne |
Powyżej zostały przedstawione dane zebrane automatycznie z treści
15 rekordów bibliograficznych,
pochodzących
z bibliotek lub od wydawców. Nie należy ich traktować jako opisu jednego konkretnego wydania lub przedmiotu.
z bibliotek lub od wydawców. Nie należy ich traktować jako opisu jednego konkretnego wydania lub przedmiotu.